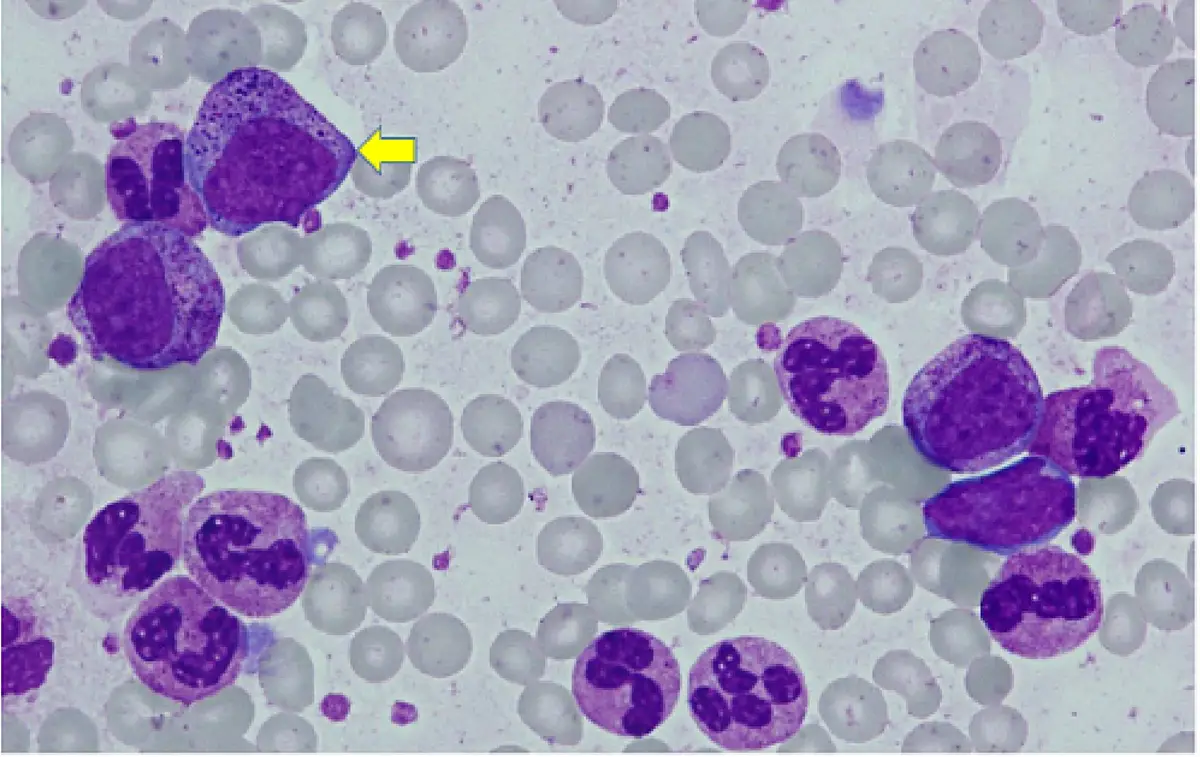
圖片

108年:(醫檢)血液(1)
承上題【35 歲男性因腹脹就醫, CBC 檢驗結果為 WBC 65.6×10 9/L 、RBC 3.05×10 12 /L 、Hb 9.1g/dL 、PLT280×10 9/L ,周邊⾎液抹片如圖,箭頭所指為下列何種細胞? 】,其 LAP score 為12 ,則此病例的⾎液細胞最可能發⽣下列那種染⾊體轉位?
At(9;22) BCR-ABL1
Bt(12;21) ETV6-RUNX1
Ct(8;21) RUNX1-RUNX1T1
Dt(15;17) PML-RARA
詳細解析
本題觀念:
本題承接前題 CML 情境(35 歲男性,WBC 65.6×10⁹/L),進一步考察白血球鹼性磷酸酶(leukocyte alkaline phosphatase, LAP)分數的臨床意義,以及 CML 特徵性染色體轉位的判讀。LAP score 為 12(正常參考範圍約 20–100,各實驗室略異)屬於明顯低值,是 CML 的重要輔助診斷依據。
影像分析:
本題所附血液抹片與上題相同,可見周邊血液中多種骨髓性成熟前驅細胞並存,包含前骨髓球、骨髓球、後骨髓球及成熟嗜中性球等全系列細胞,無 leukemic gap(maturation arrest),呈現典型 CML 慢性期(chronic phase)的周邊血液形態。此形態特徵搭配低 LAP score,高度提示 CML,需進一步以 BCR-ABL1 融合基因分析確認。
選項分析
(A) t(9;22) BCR-ABL1✅ 正確答案 t(9;22)(q34;q11.2) 為費城染色體(Philadelphia chromosome),是 CML 最重要的細胞遺傳學標記,存在於 90–95% 的 CML 患者中。此轉位使染色體 9 上的 ABL1 基因與染色體 22 上的 BCR 基因融合,產生 BCR-ABL1 融合基因,轉譯出具持續性酪胺酸激酶(tyrosine kin
...(解析預覽)...

升級 VIP 解鎖圖文解析